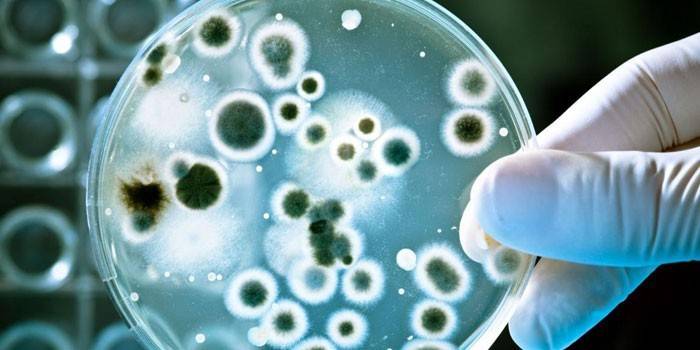

Tiberal - inštrukcie a indikácie pre použitie v čapíkoch alebo tabletách, zloženie a vedľajšie účinky lieku
S činnosťou anaeróbnych baktérií a kokov je vhodné používať liečivo Tiberal - návod na použitie, recenzie o skutočnej účinnosti lieku nájdete na mnohých lekárskych fórach. Toto lacné antibiotikum v tabletách potláča aktivitu giardie, améby, chlamydie a Trichomonas.
Z čoho sa lieči Tiberal?
Tento liek má antiprotozoálne a antimikrobiálne vlastnosti, je dostupný vo forme tabliet a je určený na orálne podávanie striktne zo zdravotných dôvodov. Tiberal lieči giardiázu, trichomoniázu, amébovú úplavicu, amébiózu, zatiaľ čo je účinnou prevenciou pooperačných komplikácií v modernej gynekológii. Terapeutický účinok je rýchly, hlavnou vecou je konzultácia s lekárom, prísne dodržiavanie predpísaných dávok.
Tiberalov pokyn
Tablety je možné zakúpiť v internetovom obchode, ale prísne je zakázané začať povrchovú samoliečbu. Inštrukcia Tiberalu nemôže byť návodom na konanie, je potrebné čakať na lekársky predpis. Droga je často predpisovaná pre dospelých a hlavnou indikáciou je exacerbácia parazitických chorôb v tele. Stabilné terapeutické účinky poskytujú účinné látky zhromaždené v jednom chemickom vzorci.
Zloženie Tiberalu
Účinná zložka, ornidazol, je účinná proti mnohým anaeróbnym baktériám a kokciám, chlamýdiam, Trichomonas, Giardia a iným patogénnym mikroorganizmom.Analógy Tiberalu s rovnakou účinnou látkou fungujú na rovnakom princípe, a preto sa pri výbere liečebného činidla ukazuje, že účinkuje individuálne. Prítomnosť pomocných látok iba zvyšuje celkový terapeutický účinok.
Tiberal tablety sa predávajú v množstve 10 kusov na jednom blistri. Po podaní jednej dávky maximálnej koncentrácie vo všetkých telesných tekutinách ornidazol dosiahne po troch hodinách. Proces rozpadu je pozorovaný v pečeni a liek a jeho neaktívne metabolity sa vylučujú v priebehu nasledujúcich 5 dní cez črevá a obličky. Je to kvôli vysokej účinnosti Tiberalu vo vzťahu k patogénnemu prostrediu.

Indikácie pre použitie
Aby sa dosiahol požadovaný účinok, je potrebné poradiť sa s lekárom o predpísanom režime intenzívnej starostlivosti. Lekárske indikácie na použitie Tiberalu sa podrobne odrážajú v pokynoch, použitie tohto lieku v kombinácii so zástupcami iných farmakologických skupín však nie je vylúčené. Tablety predpisujte na nasledujúcich klinických obrázkoch:
- trichomoniáza;
- genitourinárne infekcie;
- bakteriálne vaginóza;
- amébová úplavica;
- giardiasis;
- amébovej úplavica;
- rehabilitačné obdobie po operácii.
Vedľajšie účinky
U pacienta sa môže vyskytnúť neznášanlivosť na liečivá Tiberalu. Aby sa vylúčilo riziko vedľajších účinkov, je potrebné tieto pokyny ďalej preštudovať. Napríklad v prípade porúch fungovania centrálneho nervového systému by sa liek nemal predpisovať. Pretože tablety majú v tele systémový účinok, vedľajšie účinky Tiberalu môžu ovplyvniť všetky vnútorné orgány a systémy. Alternatívne to môžu byť tieto anomálie:
- Z tráviaceho traktu: závažné príznaky dyspepsie, bolesti brucha, pálenie záhy, ospalosť, závraty.
- Zo strany centrálneho nervového systému: kŕče, chvenie končatín, závraty, záchvaty migrény, zmätenosť.
- Z pokožky: miestne, alergické reakcie, ktoré sú dočasné.
- Z hemopoetických orgánov: príznaky neutropénie.
- Z hľadiska imunity: precitlivenosť na aktívne zložky Tiberalu.
kontraindikácie
Tiberal a alkohol sú nekompatibilné zložky, pretože pod vplyvom prvého z nich sa zvyšuje riziko intoxikácie tela pod vplyvom etylalkoholu. Toto nie je jediné obmedzenie, ktoré sa odráža v pokynoch a výrazne zužuje okruh potenciálnych pacientov. Lekárske kontraindikácie Tiberalu obmedzujú schopnosť liečby takým všeobecne prístupným spôsobom, ktoré sú podrobne opísané nižšie:
- precitlivenosť na aktívne zložky;
- vek detí;
- obdobie laktácie;
- prvý trimester gravidity;
- rozsiahle lézie centrálneho nervového systému;
- akútne neurologické choroby.
Samostatne stojí za zmienku o prijatí Tiberalu pri plodení. Klinické štúdie tejto kategórie pacientov potvrdili, že aktívna zložka liečiva nemá nepriaznivý vplyv na plod, avšak v prvom trimestri tehotenstva je stále lepšie sa takéhoto vymenovania zdržať. Na pevnejšie obdobie je povolené používať Tiberal podľa pokynov, ale pod prísnym lekárskym dohľadom. Pokiaľ ide o dojčenie, ornidazol sa vylučuje do materského mlieka.
Ako užívať Tiberal
Spôsob aplikácie a trvanie kurzu sú opísané v pokynoch, ale v závislosti od choroby je lepšie sa poradiť aj so špecialistom. Povrchná samoliečba pri odpovedi na otázku, ako užívať Tiberal, nie je vítaná. Tablety sú teda určené na perorálne podávanie, dávkovanie závisí od telesnej hmotnosti pacienta, od povahy patológie a od lekárskych predpisov.Jednotlivé dávky od výrobcu vyjadrené v pokynoch spoločnosti Tiberal sú tieto:
- dospelí - 500 mg, sa môžu zvýšiť na 2 g;
- dieťa s hmotnosťou do 35 kg - 20 - 40 mg / kg.
Ak hovoríme o intravenóznej infúzii, potom sa pri tejto metóde používajú nasledujúce denné dávky podľa vekovej kategórie pacientov:
- dospelí - 0,5 - 1 g;
- deti s hmotnosťou do 35 kg - 20 - 30 mg / kg.
S gardnerelózou
Ak je uvedená diagnóza v akútnom štádiu, ale vyznačuje sa miernymi symptómami, odporúčaný priebeh liečby nie je dlhší ako 5 dní. Tablety Tiberal na záhradné brušnice sa majú užívať jedenkrát denne - najlepšie ráno a večer. Ak je choroba chronická, maximálna dávka je 5 tabliet, ktoré je potrebné rozdeliť na 2 - 3 prístupy. Intenzívna starostlivosť trvá do úplného vymiznutia príznakov poplachu.

S chlamýdiami
Pred výberom z katalógu a objednaním špecifikovaných liekov je dôležité podrobne si prečítať pokyny. V prípade chlamydií nie je predpísaný tiberál, pretože intracelulárne mikroorganizmy - chlamýdie, ktoré svojou povahou nie sú vírusy alebo baktérie, nie sú citlivé na aktívne zložky tohto lieku. Komplikácie, ktoré spôsobujú chlamydiu v tele, sa však dajú pomocou tohto lieku odstrániť.
S giardiázou
Toto je hlavná lekárska indikácia a liečba trvá 1 - 2 dni. Ornidazol s giardiázou narušuje integritu patogénnej flóry, paralyzuje ju a podporuje produktívne vylučovanie z tela. Hlavnými výhodami sú absencia symptómov intoxikácie a rýchly terapeutický účinok. Nevýhody - droga Tiberal s giardiázou nepomáha každému, existujú lekárske kontraindikácie.
S trichomoniázou
V takom klinickom obraze sa odporúča liečiť oboch sexuálnych partnerov a denné dávky lieku sa individuálne odrážajú v pokynoch. Droga Tiberal s trichomoniázou je vysoko účinná, ženy však môžu pomocou vaginálnych čapíkov zvýšiť terapeutický účinok. Má sa liečiť 5 dní, ráno a večer, užiť jednu tabletu, vypiť vodou.
S amébiázou
Pri takejto diagnóze poskytuje inštrukcia dva liečebné režimy s ich individuálnymi charakteristikami. Ak améebická úplavica pokračuje, užívajte Tiberal 3 dni. Denná dávka pre deti je 3 tablety pre tri prístupy, pre dospelých - 4 tablety pre 2-3 prístupy. Tiberal s amébiou v komplikovaných klinických obrazoch pomôže so zvýšením intenzívnej starostlivosti na 5-10 dní a dennú dávku určí ošetrujúci lekár.
Počas tehotenstva
Pri prenášaní plodu nie je uvedený liek zakázaný. Inštrukcia uvádza, že Tiberal počas tehotenstva sa užíva iba pod lekárskym dohľadom, počnúc druhým trimestrom. Vysvetľuje to skutočnosť, že ornidazol v dostatočnom množstve preniká placentárnou bariérou, môže narušiť životne dôležité funkcie a normálnu funkčnosť embrya. Analog produktu Tiberal lacnejšie funguje na rovnakom princípe, preto nie je užitočné uskutočňovať pochybné experimenty so svojím vlastným zdravím a zdravím nenarodeného dieťaťa.
Analógy Tiberalu
Ak cena lieku nie je uspokojená, lekár vyberie lacnejšiu náhradu. Častejšie sa však používajú analógy Tiberalu so zvýšenou citlivosťou tela a jeho nekompatibilitou s aktívnymi zložkami. Pacient musí hľadať možnosti, pretože vedľajšie účinky sa prekrývajú s pretrvávajúcim terapeutickým účinkom. Analógy sú lacné, ale pred ich nákupom sa neubližuje oboznámiť sa s pokynmi. Častejšie sa jedná o tieto lieky:
- Orgil;
- Dazolik;
- Orzola;
- Lornizol;
- Ornigil;
- Meradazol;
- Ornidazol Vero;
- Meratin;
- Ornidzhil;
- ghayr;
- Ornizol;
- Ornisid;
- Ornisid Forte;
- Protozal.
Cena za Tiberal
Náklady na lieky sú prijateľné, takže liečba sa môže začať ihneď po vymenovaní Tiberala za lekára. Je vhodné kúpiť si liek v lekárni online, pretože týmto spôsobom môžete skutočne ušetriť pri kúpe. Ak nezáleží na cene Tiberalu a zaujíma vás iba dostupnosť liekov v lekárňach mesta, metropolitné ceny sú uvedené nižšie v rôznych „farmakologických bodoch“.
|
Názov lekárne v Moskve |
Cena, rubľov |
|
EliksirFarm |
750 |
|
ZdravZona |
700 |
|
Lekáreň IFC |
825 |
|
Europharm |
770 |
|
Aleksandrovskaya lekáreň |
620 |
|
Pharmacy City |
625 |
|
Medbiolayn |
670 |
Video: Tiberal Ornidazol
Ornidazol: použitie, účinnosť, liečba, vedľajšie účinky, analógy
recenzia
Maria, 35 rokov Pri améebskej úplavici dieťa sedelo na frakčnej diéte a liečivo Tiberal - inštrukcia umožňuje liečbu detí. Počas týždňa som si vzal 1 tabletu ráno a večer, výsledok bol. Príznaky rýchlo vymizli, celkový stav sa ustálil. Odporúčam vám, aby ste pokyny nepoužívali, ale aby ste okamžite navštívili detskú kanceláriu.
Alina, 27 rokov Tiberal mi pomohol s Giardiou. Vypil som jednu tabletu a zabudol som na všetky problémy. Dokonca som nešiel k lekárovi, iba som použil pokyny. Liek pôsobí rýchlo, odstraňuje nepríjemné príznaky, obnovuje radosť zo života a dobrú náladu. Tiberal si vzal na vedomie, nikdy nevieš, ja alebo deti prídem vhod viac ako raz.
Inna, 30 rokov Tento liek je úplne neúčinný. S manželom sme boli naraz liečení s Chiberalom chlamydiou, takže sme boli týmto menovaním sklamaní. Pokyny opisujú toto ochorenie, ale v skutočnosti ho liek nelieči. Iba zbytočne zbytočný čas. Musel som sa znova poradiť s lekárom a bezodkladne zmeniť režim intenzívnej starostlivosti.
Anna, 26 rokov Som alergický na pokožku na Tiberal. Keď som sa prvýkrát liečil, myslel som si, že to bola náhoda. Druhé príznaky sa objavili znova. Musel som zmeniť liečebný režim a vybrať analóg s lekárom. Je to škoda, pretože ma inštrukcia od začiatku veľmi inšpirovala. Tento liek nie je pre mňa a všetkým odporúčam, aby boli ostražití.